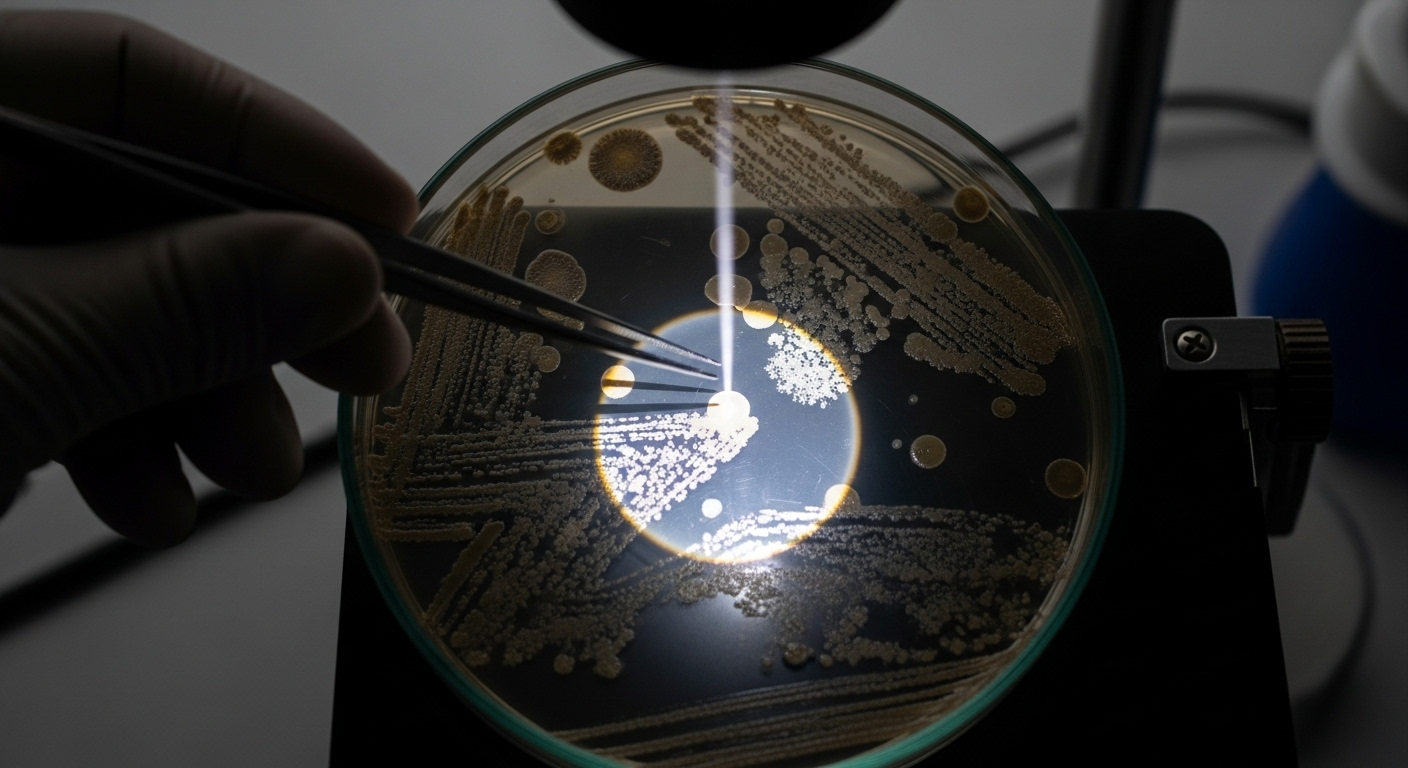
L'expérience sur les souris qui a tout révélé

Cette découverte sur les spermatozoïdes pourrait tout changer pour la fertilité masculine
Auteur: Mathieu Gagnon
Quand un couple peine à avoir un enfant, c’est souvent le début d’un long parcours, plein de questions et parfois de déceptions. On cherche la cause, on fait des examens, et pourtant, il arrive que le mystère reste entier. L’infertilité, c’est complexe. Mais figurez-vous que parfois, la réponse se cache dans quelque chose d’infiniment petit, presque invisible. Des chercheurs au Japon viennent de mettre le doigt sur un détail qui change tout, une découverte sur le fonctionnement des spermatozoïdes qui pourrait bien éclairer le chemin pour de nombreuses familles.
Le moteur du spermatozoïde : qu'est-ce qui le fait avancer ?

Pour qu’il y ait fécondation, un spermatozoïde doit accomplir un véritable marathon. Sa mission ? Atteindre l’ovule. Et pour ça, il est équipé d’un moteur très spécial : une sorte de longue queue qui ondule, un fouet qu’on appelle le flagelle. C’est grâce à lui qu’il peut nager et se propulser. Imaginez une toute petite anguille. Si sa queue ne bouge pas correctement, elle ne peut pas avancer. C’est exactement pareil pour un spermatozoïde. Un flagelle qui fonctionne mal, c’est une course perdue d’avance, et donc, une cause possible d’infertilité.
Une protéine au coeur du réacteur : CFAP91

Les scientifiques savaient déjà que la structure de ce flagelle était très compliquée. C’est une mécanique de précision ! Ils se doutaient qu’une protéine, un composant de base de notre corps, jouait un rôle important. Son petit nom : CFAP91. On la soupçonnait d’être liée à l’infertilité chez l’homme, mais personne ne savait vraiment pourquoi. C’était une pièce du puzzle, mais on ne savait pas où la mettre. C’est là que les chercheurs de l’Université d’Osaka sont entrés en scène. Ils ont décidé de tirer ce fil pour voir où il mènerait.
L'expérience sur les souris qui a tout révélé
Pour comprendre le rôle de cette fameuse protéine, les chercheurs ont mené une expérience assez directe sur des souris. Ils ont, en quelque sorte, « retiré » la protéine CFAP91 de certaines d’entre elles. Le résultat a été sans appel. Les souris sans cette protéine étaient stériles. En regardant leurs spermatozoïdes au microscope, les scientifiques ont vu que leur flagelle était mal formé et qu’ils ne bougeaient presque pas. C’était la preuve ! La protéine CFAP91 est absolument essentielle. C’est un peu comme essayer de construire un mur sans ciment. En fait, les chercheurs ont découvert que cette protéine agit comme un échafaudage : elle sert de structure de base pour que toutes les autres pièces du flagelle puissent s’assembler correctement.
Et un complice inattendu : la protéine EFCAB5

Mais l’histoire ne s’arrête pas là. Une fois qu’ils ont compris que CFAP91 était l’échafaudage, les chercheurs se sont demandé : qui sont les ouvriers ? Grâce à une technique moderne qui permet de voir quelles protéines sont « voisines » les unes des autres, ils ont découvert une complice. Une autre protéine, nommée EFCAB5, travaille main dans la main avec CFAP91. Son rôle ? Elle aide à réguler le mouvement du flagelle, à le rendre plus efficace. C’est un duo de choc : l’une construit la structure, et l’autre aide à la faire fonctionner à la perfection.
Conclusion : alors, qu'est-ce que ça change pour nous ?

Bon, tout ça, c’est de la science un peu pointue, c’est vrai. Mais les conséquences sont bien réelles. Comprendre exactement pourquoi un spermatozoïde ne fonctionne pas bien, c’est la première étape pour pouvoir un jour, peut-être, y remédier. Cette découverte n’est pas un nouveau traitement miracle, pas encore. Mais elle donne aux médecins de nouvelles pistes pour diagnostiquer plus précisément l’infertilité masculine. C’est un grand pas en avant qui redonne de l’espoir, car mieux comprendre un problème, c’est déjà commencer à le résoudre.
Selon la source : medicalxpress.com










